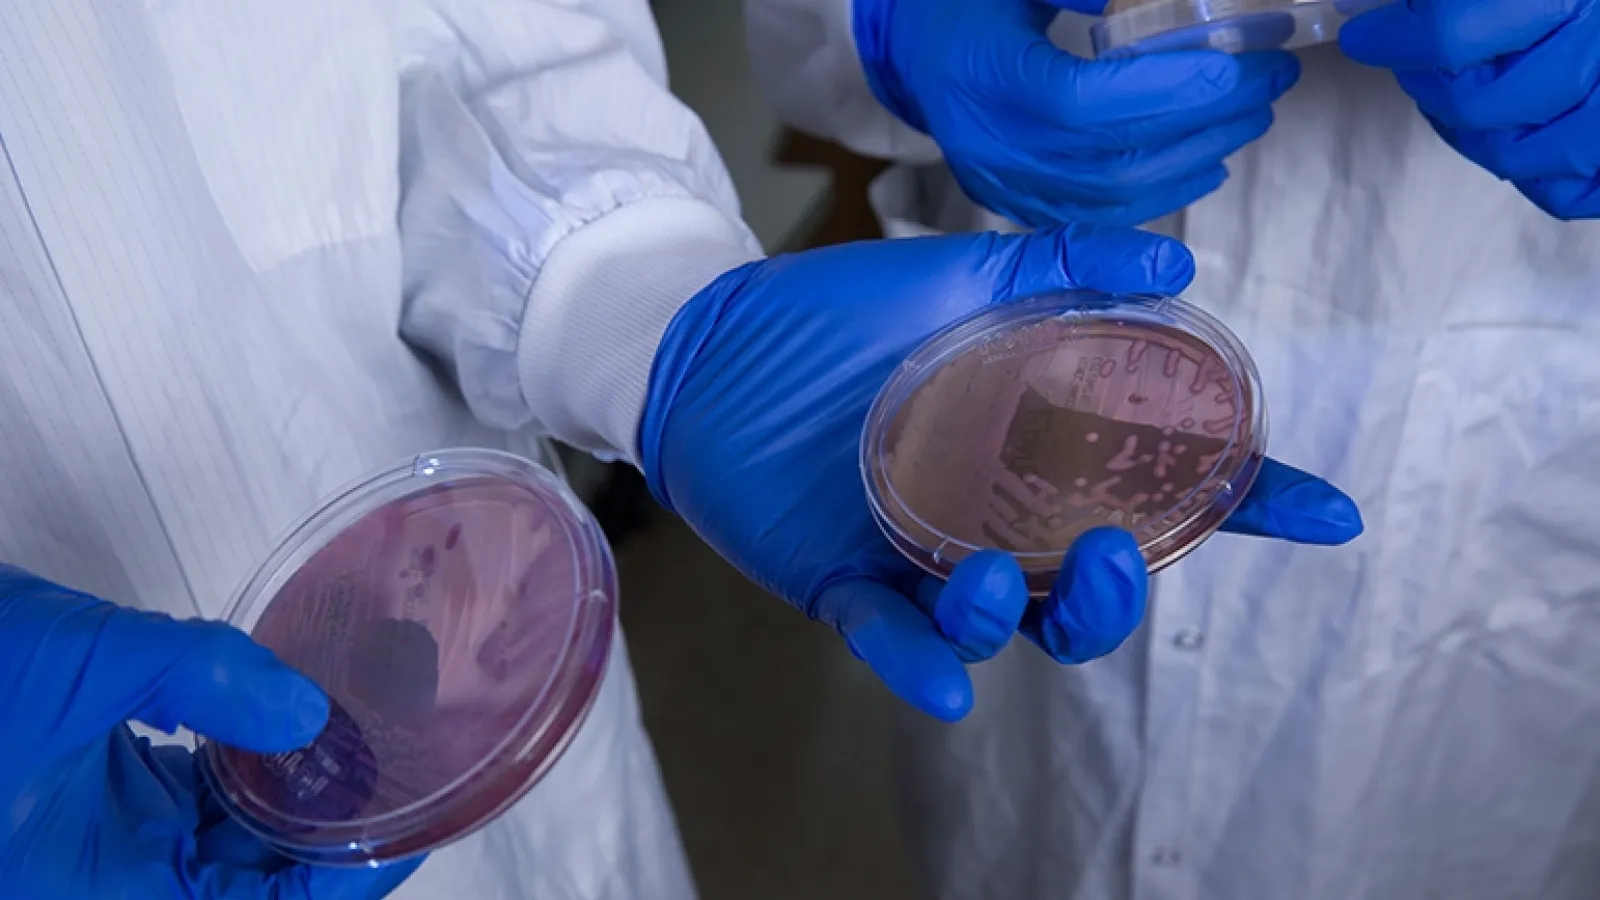
Scientist holds a Petri dish

Research
Envisioning a Brighter Future for Cancer Care
RUSH MD Anderson researchers lead investigations into the immune system’s untapped, curative potential
Researchers Use Brain Mapping to Answer Questions About What Makes Us Human
Arka Mallela, MD, MS, assistant professor, Department of Neurological Surgery, sets high ambitions for the Rush Center for Brain Mapping
Rush University Holds Fifth Annual Trainee Research Day
Day-long event highlights trainee accomplishments and transformational research happening at Rush
Changing the Way Black Boys Think About Their Future One Intervention at a Time
Chuka Emezue, PhD, MPH, is connecting boys with the tools and resources they need to rise
Investing in Faculty Excellence
Rush University celebrates five recent endowed faculty appointments and three endowed faculty scholar positions established and made possible by philanthropy
Exploring the Latest Topics in Sports
The 2025 Chicago Sports Summit will cover Formula 1, caring for top athletes, the demands of youth sports and more, while supporting orthopedic research at Rush
Channeling Marathon Miles Into Hope and New Solutions
From surgeons to students, Team Rush runners are taking on the Chicago Marathon to raise funds for the programs and patients closest to their hearts
'It Really Sets Us Apart'
Cell therapy program tests bold, innovative solutions for cancers and chronic diseases
Rush to Serve as Elite Infectious Disease Center
Illinois will fund $1.5 million to upgrade Rush and Lurie Children’s capacity to treat high-consequence pathogens
Honoring Christopher G. Goetz, MD
The force behind Rush’s powerhouse Parkinson’s disease and movement disorders program